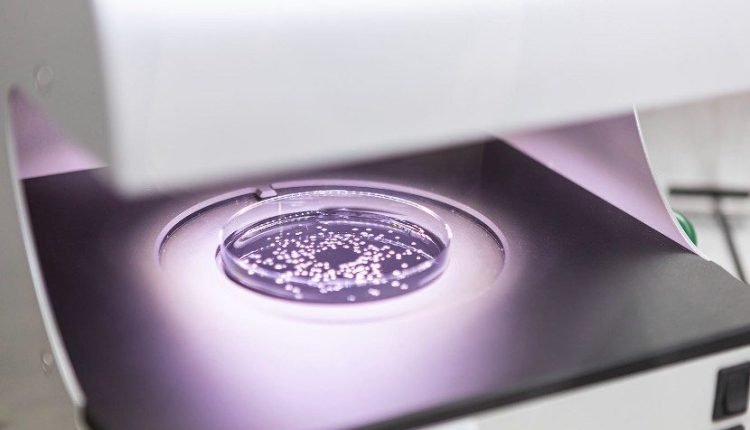

A Syngenta e a Amoéba anunciaram na segunda-feira, 17, a assinatura de um Memorando para o desenvolvimento e comercialização de soluções de biocontrole na União Europeia e no Reino Unido
A parceria foca em tecnologias baseadas na ameba Willaertia magna C2c Maky para proteção de cultivos de cereais. As empresas planejam negociar um acordo definitivo de distribuição até a primavera de 2026.
O foco inicial da colaboração será o combate a doenças do trigo, especificamente a mancha de septoria (STB) e a ferrugem amarela.
Segundo dados do comunicado, essas enfermidades atingem entre 9 milhões e 12 milhões de hectares na Europa anualmente.
Na Alemanha, a STB gera custos de 1,5 bilhão de euros por ano e perdas de produtividade de até 50%.
A tecnologia desenvolvida pela Amoéba atua como um biofungicida que ativa as defesas das plantas.
A substância recebeu aprovação da Comissão Europeia em junho de 2025, após avaliação da Autoridade Europeia para a Segurança dos Alimentos (EFSA). Em outubro, o produto recebeu a Medalha de Ouro Bernard Blum na categoria de biocontrole.
*Conteúdo gerado com auxílio de Inteligência Artificial, revisado e editado pela Redação do Broadcast, sistema de notícias em tempo real do Grupo Estado
VEJA MAIS:
- Como facções criminosas usam o agronegócio para lavagem de dinheiro
- Você sabe como começou a história do Mangalarga Marchador no Brasil?
ℹ️ Conteúdo publicado pela estagiária Ana Gusmão sob a supervisão do editor-chefe Thiago Pereira
Quer ficar por dentro do agronegócio brasileiro e receber as principais notícias do setor em primeira mão? Para isso é só entrar em nosso grupo do WhatsApp (clique aqui) ou Telegram (clique aqui). Você também pode assinar nosso feed pelo Google Notícias
Não é permitida a cópia integral do conteúdo acima. A reprodução parcial é autorizada apenas na forma de citação e com link para o conteúdo na íntegra. Plágio é crime de acordo com a Lei 9610/98.
